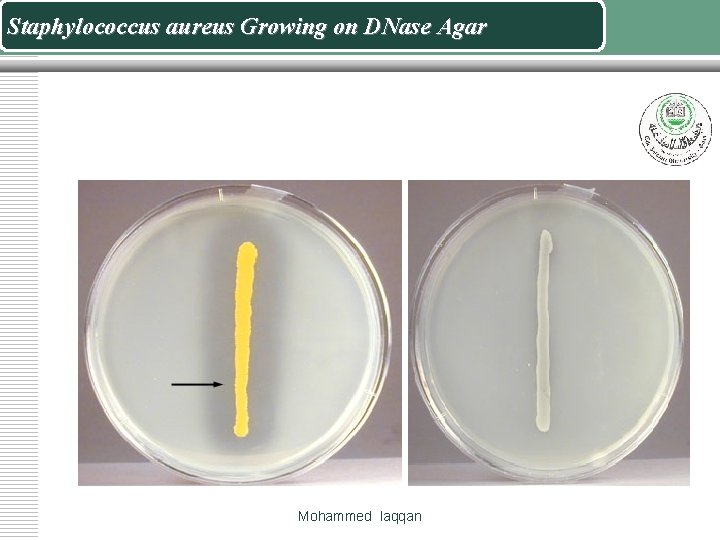
Staphylococcus aureus Growing on DNase Agar Mohammed laqqan
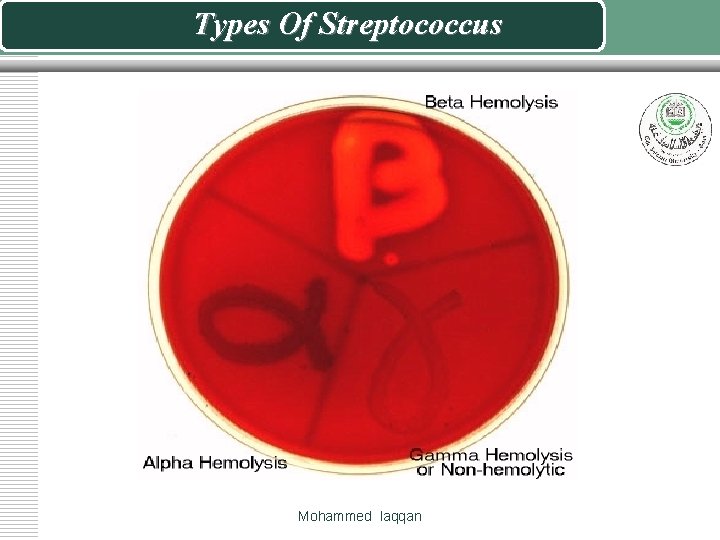
Types Of Streptococcus Mohammed laqqan

General Microbiology Laboratory Isolation and Identification of Gram

General Microbiology Laboratory Isolation and Identification of Gram Positive Cocci

Identified method for Staphylococci v. Gram-stain v Isolation and culture v Pure culture v Direct identification Mohammed laqqan

Staphylococci are Gram-positive cocci, typically arranged in clumps or Grape-like clusters Mohammed laqqan

Direct identification v. Coagulase Test v. Mannitol fermentation test. v. DNase Test v Novobiocin (NB) disc Mohammed laqqan

Test Staphylococcus aureus Staphylococcus epidermidis Mannitol fermentation Positive Negative Mohammed laqqan Staphylococcus saprophyticus Usually positive

The DNase Test v Inoculate DNase agar plates with a loop so that the growth is in plaques about 1 cm in diameter. I v ncubate at 370 C overnight. v Flood the plate with 1 N hydrochloric acid. Clearing around the colonies indicates DNase activity. v The hydrochloric acid reacts with unchanged deoxyribonucleic acid to give a cloudy precipitate. v A few other bacteria, e. g. Serratia, may give a positive reaction. Mohammed laqqan
Staphylococcus aureus Growing on DNase Agar Mohammed laqqan

Blood agar with a novobiocin (NB) disc Staphylococcus aureus Growing on Blood Agar Staphylococcus saprophyticus Growing on Blood Agar S R Mohammed laqqan
Types Of Streptococcus Mohammed laqqan

(β) Haemolytic Streptococcus groups v S. pyogenes • Group A v S. agalactiae • Group B (occasionally α or none) v Streptococcus bovis • Group D (α or none, occasionally β) Mohammed laqqan

Group A strep: S. pyogenes v Gram +ve cocci v Catalase (+ve) v Small, round, grey colonies v β-haemolysis v zone is large v Group A antigen Mohammed laqqan

Isolation and Identification of (Streptococcus pyogenes) 1. on Blood agar. Streptococcus pyogenes produces a zone of beta hemolysis around 2 -3 mm in diameter surrounding each colony 2. Sensitivity to the antibiotic bacitracin 3. Group A Strep is senstive, other b haemolytic streps are resistant. Mohammed laqqan

Bacitracin sensitivity Mohammed laqqan

Identification of Streptococci Mohammed laqqan

Group B: S. agalactiae Identification v Catalase negative v. Bacitracin resistant v CAMP positive v Growth on Mac (weak) v. Appearance on BA v Larger colonies than Group A v Small zone of hemolysis Mohammed laqqan

CAMP test v The “CAMP” test (acronym for developers) is used to differentiate S. agalactiae (GBS), which is positive, from other beta hemolytic strep, all of which are negative v “CAMP factor” is a soluble hemolysin produced by GBS that combines in a synergistic way with a similar hemolysin of S. aureus to form an arrowhead zone of clearing. v The staph is streaked perpendicularly to the unknown strep. After appropriate incubation time an “arrowhead-shaped” clear zone of hemolysis will appear. Mohammed laqqan

S. agalactiae §Synergistic haemolysis observed between betahemolytic Staphylococcus aureus and group B streptococci. �� Positive reaction: arrowhead haemolysis pattern Mohammed laqqan

α – Haemolytic streps: Viridans streps v. Not groupable by Lancefield groups v No group specific CHO v Streptococcus pneumoniae v Primary human pathogen v. S. sanguis v S. mitis v S. mutans Mohammed laqqan

Mohammed laqqan

The Pneumococcus (Streptococcus pneumoniae) 1: Isolation on Blood agar • Pneumococci frequently require enriched media and increased CO 2 tension for initial isolation. • They are usually isolated on Blood agar and incubated in a candle jar (a closed container in which a lit candle is placed to remove O 2 and increase CO 2 ) at 37 C. On Blood agar, colonies appear small, shiny, and translucent. • They are surrounded by a zone of alpha hemolysis 2: Optochin sensitivity • Pneumococci are the only streptococci that are sensitive to the drug optochin. 3: Gram stain: gram-positive, diplococci Mohammed laqqan

Mohammed laqqan

The Genus Enterococcus v Enterococci are gram-positive streptococci, typically occurring in pairs and short chains, that are normal flora of the intestinal tract. Enterococci responsible for a variety of opportunistic infections in humans, and serologically belong to Lancefield group D streptococci. v On Bile Esculin agar v Unlike most bacteria, the enterococci will grow in the presence of the bile salts in the medium. v They hydrolyze the esculin, producing esculetin which reacts with the iron salts in the medium turning the agar black Mohammed laqqan

Mohammed laqqan

Enterococcus Mohammed laqqan

Enterococcus v. White colonies v Alpha and no haemolysis (rarely beta) v Also grow on Mac. Conkey v Resembles S. pneumoniae in Gram stains v Bile esculin positive v Grows on Mac Mohammed laqqan


End of lecture Mohammed laqqan
- Slides: 27